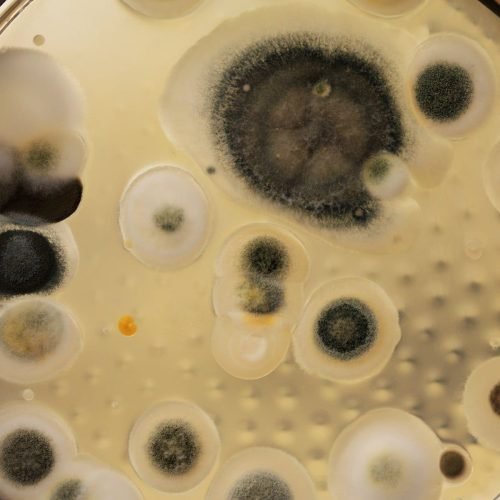
Conheça os principais tipos de mofo encontrados em casa

Want to Partnership with me? Book A Call
Popular Posts
- All Post
- Devops
- Finanças
- Futebol
- Sem categoria
- Tecnologia
Dream Life in Paris
Questions explained agreeable preferred strangers too him her son. Set put shyness offices his females him distant.
Questions explained agreeable preferred strangers too him her son. Set put shyness offices his females him distant.

Enquanto Amazon, Google, Microsoft, Apple e Tesla decepcionam Wall Street com resultados abaixo das expectativas, a Meta segue em disparada. As ações da empresa já subiram 22% este ano, impulsionadas pelo sucesso de...

Apesar de acreditar na tecnologia da World, Cristiano afirma ter sido enganado, pois foi informado por um funcionário da World de que receberia cerca de R$ 300 por mês. Assim como os demais,...

A Israel Weapon Industries (IWI) lançou recentemente novos rifles equipados com o sistema ARBEL de última geração, apresentando avanços no combate de infantaria, fogo de supressão guiado com maior precisão e ferramentas antidrones....

Vidas Passadas (ou Past Lives, no original) é um filme de drama lançado em 2023 que chamou a atenção do público e da crítica pela trama delicada e atuações sensíveis. Dirigido pela cineasta...

Enquanto gigantes como a Warner e Amazon se aproveitam de universos de fantasia como Game of Thrones e Senhos dos Anéis, a Netflix viu na obra do polonês Andrzej Sapkowski uma franquia para...

O clima da Terra é influenciado por diferentes processos que ocorrem tanto no planeta quanto fora dele. Afinal, sem o Sol, não receberíamos a luz e o calor essenciais para manter uma temperatura...

O CEO da OpenAI, Sam Altman, revelou hoje (12) os planos em relação aos modelos GPT-4.5 e GPT-5, as próximas atualizações da inteligência artificial generativa da startup. Ele também comentou sobre o desejo...

Leslie Benzies, ex-presidente da Rockstar North e produtor responsável por jogos como GTA e Red Dead Redemption, deixou a empresa em 2016. Dois anos depois, em 2018, o executivo fundou seu próprio estúdio,...
O mofo é uma formação de vários tipos de fungos filamentosos comuns na natureza ou em casa. Por trás de sua aparência inofensiva — e estranha — esses microrganismos podem ser uma dor...

(Reuters) – A rede social X, de Elon Musk, concordou em pagar cerca de US$10 milhões para resolver um processo que o presidente dos Estados Unidos, Donald Trump, moveu contra a empresa e...

Fechando a última edição do State of Play, a Housemarque anunciou seu mais novo jogo com um trailer impressionante — Saros. Estrelando o ator Rahul Kohli, conhecido por Missa da Meia-Noite e Maldição...

Gritar tão alto a ponto de seus pulmões quase colapsarem e você parar no hospital foi o que aconteceu com uma adolescente após ela ir ao show da banda One Direction. O caso...

Durante o último State of Play, a Supermassive Games revelou seu novo jogo — Directive 8020. Situado no espaço, o título acompanha a tripulação de uma nave infestada por uma forma de vida...

O State of Play desta quarta (12) trouxe grandes surpresas aos fãs de anime, sobretudo aqueles entusiastas dos bichinhos virtuais. A Bandai Namco usou o palco do primeiro evento de PlayStation de 2025...

Anunciado originalmente em 2017, o RPG de ação Lost Soul Aside, inspirado em grandes clássicos dos videogames como Final Fantasy e Devil May Cry, percorreu um longo caminho até aqui. Bem, depois de...

O Governo Federal apresentou nesta terça-feira (11) uma nova plataforma digital para microempreendedores individuais cadastrados como MEI. O serviço se chama Contrata+Brasil e é visto como uma nova forma de gerar renda e,...

A Amazon confirmou que realizará um evento em 26 de fevereiro para anunciar novidades em sua linha de produtos. Por mais que a gigante não tenha citado o que deve ser revelado, é...

Este texto foi escrito por um colunista do TecMundo; saiba mais no final. A recente série documental Arnold, na Netflix, traz a vida e a carreira multifacetada de Arnold Schwarzenegger em três episódios,...

A onda de calor prevista para ocorrer a partir desta quarta-feira (12), prevalecendo até o dia 21 de fevereiro, deve fazer com que as temperaturas cheguem a mais de 40 °C em várias cidades...

Imagem: Divulgação/Netflix Lançada na última terça-feira (11) pela Netflix, The Witcher: Sereias das Profundezas é a mais nova animação inspirada no universo criado por Andrzej Sapkowski. A obra mostra um novo conto estrelado...

O apetite não humorado voltou informado. Posse, comparação, inquietação, ele não convence de forma decisiva.

© 2025 Created TI Project